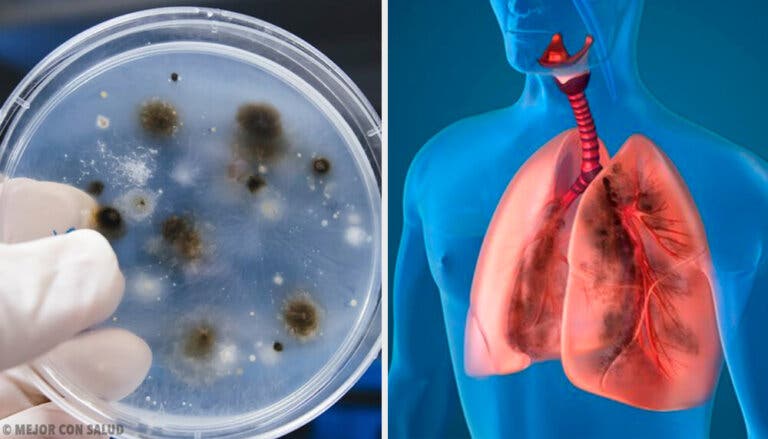

La aspergilosis

Revisado y aprobado por el médico José Gerardo Rosciano Paganelli
El Aspergillus fumigatus es el patógeno responsable de más del 80% de las aspergilosis. Se trata de un hongo filamentoso de distribución muy amplia que abunda sobre todo en zonas húmedas con restos orgánicos, como hojas muertas o estiércol. También se encuentra en los granos almacenados y en las hojas de marihuana.
Por lo tanto, las aspergilosis son todas aquellas enfermedades producidas por los hongos de este género. Por lo general, afecta a las personas con el sistema inmunitario debilitado, es decir, personas con bajas defensas.
Se transmite a través de la inhalación de las esporas del hongo. A partir de entonces, la invasión se dirige, principalmente, hacia los vasos sanguíneos.
Factores de riesgo
- La neutropenia.
- Los tratamientos con fármacos inmunosupresores, por ejemplo los corticoides.
- Las neoplasias hematológicas: leucemias, linfomas, neoplasias mieloproliferativas inclasificables, entre otras.
- Inmunosupresión post-trasplante. En pacientes que necesitan un trasplante de órganos es necesaria una inmunosupresión previa para disminuir las posibilidades de rechazo.
- Enfermedades inmunológicas, que afecten directamente a las defensas, como puede ser el SIDA. Es frecuente que los pacientes con VIH tengan aspergilosis.
Además de los factores de riesgo relacionados con el sistema inmunitario y las defensas, existen enfermedades crónicas pulmonares que predisponen a padecer este tipo de infecciones, como la fibrosis quística o la enfermedad pulmonar obstructiva crónica (EPOC).
Descubre: Enfermedad pulmonar obstructiva crónica (EPOC)
Principales formas clínicas de las aspergilosis

Existen diversos cuadros en cuya patogenia participa el hongo Aspergillus. La aparición de uno u otro depende del grado de afectación inmune y de la localización del hongo. A continuación, mencionaremos las aspergilosis más características:
- No invasivas:
- Aspergiloma.
- Aspergilosis broncopulmonar alérgica (ABPA).
- Invasivas:
- Aspergilosis pulmonar invasiva.
- Aspergilosis traqueobronquial.
- Otros cuadros de aspergilosis.
Aspergiloma

En este caso, el hongo crece en cavidades pulmonares ya existentes, de distintas etiologías, junto con restos celulares, mocos y fibrina. Aparece una colección delimitada (con cápsula) que cursa sin síntomas en un 20% de los pacientes. Eventualmente puede aparecer en los senos paranasales.
Dichas cavidades pueden proceder de infecciones antiguas como una tuberculosis, quistes, bullas enfisematosas (son unas cámaras de aire en el pulmón debido a destrucción o desplazamiento de las estructuras bronquiales distales, aparecen en enfermedades pulmonares como la EPOC) o como consecuencia de un carcinoma pulmonar.
La clínica de estos pacientes, si existe, suele consistir en tos no productiva, sin emisión de esputo o moco, y, a veces, sanguinolenta (hemoptisis).
El diagnóstico viene dado por una radiografía de tórax en la que se detallarán las cavidades. A veces, los cultivos para el hongo son negativos, así que puede confirmarse mediante la presencia de inmunoglobulinas específicas contra el mismo.
El tratamiento suele ser quirúrgico en casos que cursan con hemoptitis repetitivas. Pueden asociarse fármacos antifúngicos.
Descubre: 10 señales de que tus pulmones pueden estar fallando
Aspergilosis broncopulmonar alérgica (ABPA)
Se trata de una reacción alérgica contra las especies de Aspergillus. Es una patología que aparece principalmente en pacientes asmáticos y con fibrosis quística.
Las sustancias liberadas durante la reacción alérgica producen una obstrucción de la vía aérea, con tos productiva (expulsa moco) asociada o no a fiebre y anorexia, además de la clínica asmática. Si no se trata, puede evolucionar a fibrosis pulmonar con bronquiectasias.
El diagnóstico se sospecha por la clínica en pacientes asmáticos, confirmándolo con pruebas alérgicas cutáneas para Aspergillus, así como la medición de precipitinas, eosinofilia y otros parámetros que apoyen la alergia.
El objetivo en el tratamiento de la aspergilosis broncopulmonar alérgica es evitar el agravamiento del asma o la fibrosis quística existentes. Por eso, se trata con corticosteroides orales.
Los medicamentos antifúngicos por sí solos no sirven para tratar esta afección, aunque se suelen combinar con los corticosteroides para reducir la dosis y mejorar la función pulmonar.
Aspergilosis pulmonar invasiva

Se trata de un cuadro grave y frecuente, aparece principalmente en pacientes con neutropenia y trasplantados de médula ósea.
Cuando el hongo llega al alveolo pulmonar, los macrófagos no pueden frenar la infección y se propaga. Produce necrosis del tejido pulmonar y puede diseminarse, a través de los vasos pulmonares, hacia el cerebro. En las zonas lesionadas puede producir infartos hemorrágicos.
Estos pacientes van a presentar fiebre, dolor torácico, tos no productiva, hemoptisis y disnea (dificultad para respirar). En la radiografía pulmonar es característico el signo de halo, un nódulo rodeado de un disco radiolúcido. Puede cavitarse.
En cuanto al tratamiento, el uso de fármacos antifúngicos es clave. Y hay que señalar que, sin tratamiento, el pronóstico es fatal. Por ello, la mortalidad ronda cerca del 100%
Aspergilosis traqueobronquial
Aunque es una infección invasora, tiene mejor pronóstico que la aspergilosis pulmonar invasiva. Un 10% afecta a sujetos sin inmunodepresión. En este caso, la presencia de Aspergillus provoca lesiones ulcerativas y con pseudomembranas en la mucosa de las vías respiratorias.
La afectación alveolar es escasa. Además de la clínica de tos, hemoptitis y fiebre, destaca un profundo estridor debido a la ocupación de la vía aérea. Es un cuadro grave que, si no se trata, puede llevar a la muerte del paciente, por la expansión de la infección. A veces, puede incluso romper la vía aérea.
Otros cuadros por Aspergillus
Aunque es menos frecuente, las aspergilosis pueden tener otras localizaciones además de la pulmonar. Cuando el hongo se adquiere por vía sanguínea, puede afectar a cualquier estructura.
Destaca la afectación de los senos paranasales, aguda o crónica, y las aspergilosis del sistema nervioso central, que cursan con abscesos cerebrales.
El Aspergillus fumigatus es el patógeno responsable de más del 80% de las aspergilosis. Se trata de un hongo filamentoso de distribución muy amplia que abunda sobre todo en zonas húmedas con restos orgánicos, como hojas muertas o estiércol. También se encuentra en los granos almacenados y en las hojas de marihuana.
Por lo tanto, las aspergilosis son todas aquellas enfermedades producidas por los hongos de este género. Por lo general, afecta a las personas con el sistema inmunitario debilitado, es decir, personas con bajas defensas.
Se transmite a través de la inhalación de las esporas del hongo. A partir de entonces, la invasión se dirige, principalmente, hacia los vasos sanguíneos.
Factores de riesgo
- La neutropenia.
- Los tratamientos con fármacos inmunosupresores, por ejemplo los corticoides.
- Las neoplasias hematológicas: leucemias, linfomas, neoplasias mieloproliferativas inclasificables, entre otras.
- Inmunosupresión post-trasplante. En pacientes que necesitan un trasplante de órganos es necesaria una inmunosupresión previa para disminuir las posibilidades de rechazo.
- Enfermedades inmunológicas, que afecten directamente a las defensas, como puede ser el SIDA. Es frecuente que los pacientes con VIH tengan aspergilosis.
Además de los factores de riesgo relacionados con el sistema inmunitario y las defensas, existen enfermedades crónicas pulmonares que predisponen a padecer este tipo de infecciones, como la fibrosis quística o la enfermedad pulmonar obstructiva crónica (EPOC).
Descubre: Enfermedad pulmonar obstructiva crónica (EPOC)
Principales formas clínicas de las aspergilosis

Existen diversos cuadros en cuya patogenia participa el hongo Aspergillus. La aparición de uno u otro depende del grado de afectación inmune y de la localización del hongo. A continuación, mencionaremos las aspergilosis más características:
- No invasivas:
- Aspergiloma.
- Aspergilosis broncopulmonar alérgica (ABPA).
- Invasivas:
- Aspergilosis pulmonar invasiva.
- Aspergilosis traqueobronquial.
- Otros cuadros de aspergilosis.
Aspergiloma

En este caso, el hongo crece en cavidades pulmonares ya existentes, de distintas etiologías, junto con restos celulares, mocos y fibrina. Aparece una colección delimitada (con cápsula) que cursa sin síntomas en un 20% de los pacientes. Eventualmente puede aparecer en los senos paranasales.
Dichas cavidades pueden proceder de infecciones antiguas como una tuberculosis, quistes, bullas enfisematosas (son unas cámaras de aire en el pulmón debido a destrucción o desplazamiento de las estructuras bronquiales distales, aparecen en enfermedades pulmonares como la EPOC) o como consecuencia de un carcinoma pulmonar.
La clínica de estos pacientes, si existe, suele consistir en tos no productiva, sin emisión de esputo o moco, y, a veces, sanguinolenta (hemoptisis).
El diagnóstico viene dado por una radiografía de tórax en la que se detallarán las cavidades. A veces, los cultivos para el hongo son negativos, así que puede confirmarse mediante la presencia de inmunoglobulinas específicas contra el mismo.
El tratamiento suele ser quirúrgico en casos que cursan con hemoptitis repetitivas. Pueden asociarse fármacos antifúngicos.
Descubre: 10 señales de que tus pulmones pueden estar fallando
Aspergilosis broncopulmonar alérgica (ABPA)
Se trata de una reacción alérgica contra las especies de Aspergillus. Es una patología que aparece principalmente en pacientes asmáticos y con fibrosis quística.
Las sustancias liberadas durante la reacción alérgica producen una obstrucción de la vía aérea, con tos productiva (expulsa moco) asociada o no a fiebre y anorexia, además de la clínica asmática. Si no se trata, puede evolucionar a fibrosis pulmonar con bronquiectasias.
El diagnóstico se sospecha por la clínica en pacientes asmáticos, confirmándolo con pruebas alérgicas cutáneas para Aspergillus, así como la medición de precipitinas, eosinofilia y otros parámetros que apoyen la alergia.
El objetivo en el tratamiento de la aspergilosis broncopulmonar alérgica es evitar el agravamiento del asma o la fibrosis quística existentes. Por eso, se trata con corticosteroides orales.
Los medicamentos antifúngicos por sí solos no sirven para tratar esta afección, aunque se suelen combinar con los corticosteroides para reducir la dosis y mejorar la función pulmonar.
Aspergilosis pulmonar invasiva

Se trata de un cuadro grave y frecuente, aparece principalmente en pacientes con neutropenia y trasplantados de médula ósea.
Cuando el hongo llega al alveolo pulmonar, los macrófagos no pueden frenar la infección y se propaga. Produce necrosis del tejido pulmonar y puede diseminarse, a través de los vasos pulmonares, hacia el cerebro. En las zonas lesionadas puede producir infartos hemorrágicos.
Estos pacientes van a presentar fiebre, dolor torácico, tos no productiva, hemoptisis y disnea (dificultad para respirar). En la radiografía pulmonar es característico el signo de halo, un nódulo rodeado de un disco radiolúcido. Puede cavitarse.
En cuanto al tratamiento, el uso de fármacos antifúngicos es clave. Y hay que señalar que, sin tratamiento, el pronóstico es fatal. Por ello, la mortalidad ronda cerca del 100%
Aspergilosis traqueobronquial
Aunque es una infección invasora, tiene mejor pronóstico que la aspergilosis pulmonar invasiva. Un 10% afecta a sujetos sin inmunodepresión. En este caso, la presencia de Aspergillus provoca lesiones ulcerativas y con pseudomembranas en la mucosa de las vías respiratorias.
La afectación alveolar es escasa. Además de la clínica de tos, hemoptitis y fiebre, destaca un profundo estridor debido a la ocupación de la vía aérea. Es un cuadro grave que, si no se trata, puede llevar a la muerte del paciente, por la expansión de la infección. A veces, puede incluso romper la vía aérea.
Otros cuadros por Aspergillus
Aunque es menos frecuente, las aspergilosis pueden tener otras localizaciones además de la pulmonar. Cuando el hongo se adquiere por vía sanguínea, puede afectar a cualquier estructura.
Destaca la afectación de los senos paranasales, aguda o crónica, y las aspergilosis del sistema nervioso central, que cursan con abscesos cerebrales.
Todas las fuentes citadas fueron revisadas a profundidad por nuestro equipo, para asegurar su calidad, confiabilidad, vigencia y validez. La bibliografía de este artículo fue considerada confiable y de precisión académica o científica.
- Peman, J. (1999). Aspergilosis. Revista Espanola de Quimioterapia. https://doi.org/10.1016/B978-84-8086-971-3/00347-8
- Fortún, J., Meije, Y., Fresco, G., & Moreno, S. (2012). Aspergilosis. Formas clínicas y tratamiento. Enfermedades Infecciosas y Microbiologia Clinica. https://doi.org/10.1016/j.eimc.2011.12.005
- Alcalá, L., Muñoz, P., Peláez, T., & Bouza, E. (2015). Aspergillus y aspergilosis. SEIMC.
Este texto se ofrece únicamente con propósitos informativos y no reemplaza la consulta con un profesional. Ante dudas, consulta a tu especialista.









